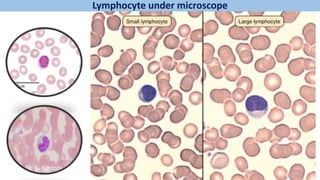
Lymphocyte under microscope

The document provides an overview of the circulatory system, detailing the composition and functions of blood, which includes transportation, regulation, and protection. It explains the types of blood cells—red blood cells, white blood cells, and platelets—along with their structures, functions, and life cycles, and also covers important processes like erythropoiesis, hemolysis, and hemostasis. Additionally, the document discusses blood groups and associated disorders such as anemia and polycythemia.